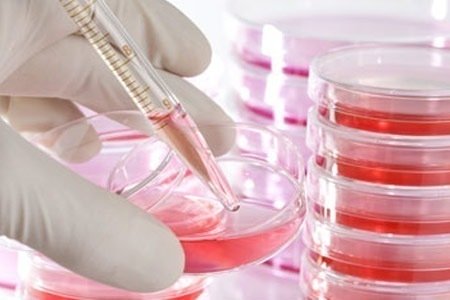

La hipercolesterolemia familiar es una enfermedad silenciosa, que muchas veces se hace visible a través de sus consecuencias más drásticas: ataques cardiacos, ictus o trombosis. De hecho, la mayoría de los infartos de personas menores de 50 años se debe a una hipercolesterolemia genética sin diagnosticar
Barcelona, 5 de diciembre de 2012 (Medicosypacientes.com)
El diagnóstico precoz es la única opción para controlar los efectos de esta enfermedad y permitir una mejor calidad de vida a las personas que la padecen, así como un ahorro a la sanidad pública. Se estima que en España más de 875.000 personas tienen hipercolesterolemia familiar, sin embargo el 80% ni siquiera sabe que la padece.
Desde la Sociedad Española de Arteriosclerosis el mensaje es claro: «La prevención es la clave y, hoy en día, existen técnicas que permiten detectar esta dolencia con una simple muestra de saliva. Además, al tratarse de una enfermedad genética, la prueba sólo se realiza una vez en la vida».
Actualmente, existen diferentes niveles de implantación de métodos de diagnóstico en las comunidades autónomas, a la hora de detectar esta enfermedad y evitar sus consecuencias. Así, las comunidades autónomas más implicadas son Madrid y Castilla León, ya que cuentan con plan de diagnóstico precoz y han convocado concursos durante los dos últimos años para suministrar estas técnicas a sus hospitales. Aragón, Cataluña y País Vasco también cuentan con iniciativas en este sentido, suministrando estas técnicas a los hospitales propiciando la actividad rutinaria respecto a la hipercolesterolemia familiar.
«Creemos que es indispensable poner en marcha un Plan de Diagnóstico Nacional que conciencie al sistema sanitario de la importancia de utilizar estas técnicas». Además, según la Sociedad Española de Arterosclerosis, la prevención supondría un mejor control de los enfermos y un ahorro a largo plazo para las arcas públicas, al evitar los efectos graves que provoca: ataques cardiacos, ictus, trombosis e, incluso, la muerte.
Recomendaciones internacionales
En el año 1997 la Organización Mundial de la Salud emitió su primer informe sobre el manejo de la hipercolesterelomia familiar. Posteriormente desde Estados Unidos el Proyecto MEDPED, recomendaba la necesidad de un diagnóstico temprano como herramienta fundamental de prevención. Recientemente la Sociedad Europea de Cardiología y La Asociación Europea para la Prevención y Rehabilitación Cardiovascular también se han unido a estas recomendaciones.
En este sentido, países como Holanda cuentan, desde 1994, con un Plan de Detección Nacional de Hipercolesterolemia Familiar (Cascada Familiar). Entre los beneficios obtenidos: el 85% de los pacientes diagnosticados siguen un tratamiento adecuado para normalizar sus niveles de colesterol, viéndose reducido el riesgo de sufrir un ataque al corazón prematuro en un 80%. Se estiman que las personas diagnosticadas por el Plan de Detección Nacional han alargado su esperanza de vida en más de 3 años. Además, gracias al plan se evitan 26 infartos de miocardio por cada 100 pacientes diagnosticados y tratados con edades comprendidas entre 18 y 60 años.